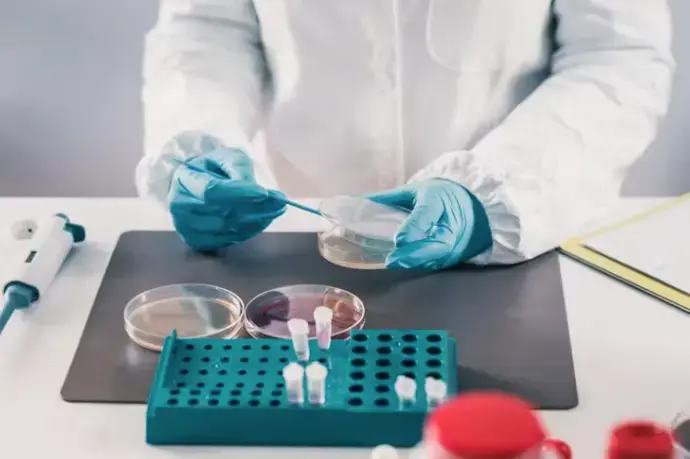

Applied Biosystems 7500 FAST Dx Real Time PCR System
In Stock
Product Code: ABI-7500

Meet your sales rep Lee Doughton, for the West USA region.
Would you like to schedule a 15-minute consultation with Lee Doughton?
Yes, Schedule a callUser-friendly, high-speed thermal cycling qPCR system
Brand-new and used ABI 7500 PCR systems available to fit your budget.
Block Scientific provides ABI PCR instrumentation services, multi-year service contracts, and supplies reagents and consumables.
We are committed to helping your lab be more profitable by assisting in cost control.
Request a quote to see the total cost of ownership for your ABI 7500 in 90 minutes.
FAST & accurate results with Applied Biosystems 7500
30 minutes is all it takes for the ABI 7500 Fast Real-Time PCR System to deliver high-quality results.
It supports various applications, including:
Gene expression analysis
SNP genotyping
High-resolution melting (HRM) analysis.
What makes the Applied Biosystems 7500 stand out?
- Its software is user-friendly, including advanced analysis tools and robust security features for 21 CFR Part 11 compliance.
- The system features a specially designed fast block, rapid ramp rates, and compatibility with multiple dye sets.
- It also offers extensive validation support and a comprehensive suite of TaqMan® assays for gene expression and SNP genotyping.
The ABI 7500 is great for any labs that are looking for a versatile and scalable PCR system for the next decade.
Flexible Applied Biosystems 7500 PCR Systems
Three PCR systems designed to cater for your lab’s throughput and budget
Whether you need rapid results, versatile dye flexibility, or compliance with diagnostic standards, there is an ABI 7500 model suited to your specific requirements.
ABI 7500 Fast Real-Time PCR System
This model delivers results in as little as 30 minutes, ideal for labs that need quick turnaround times.
Key features:
High-quality results in 30 minutes
Fast ramp rates for quick results
Fast block design for thermal uniformity
Precision in small reaction volumes (5-30 μL)
ABI 7500 Real-Time PCR System
The standard ABI 7500 Real-Time PCR System offers robust performance for a wide range of applications.
Key Features:
Five-color dye flexibility
Advanced multicomponenting algorithm to minimize spectral crosstalk
User-friendly software with advanced analysis tools
Comprehensive application support, including gene expression analysis, absolute quantitation, and SNP genotyping
ABI 7500 Fast Dx Real-Time PCR System
Tailored for in vitro diagnostic use, this model includes additional compliance features to meet regulatory standards, making it an excellent choice for clinical labs focused on diagnostic research.
Key Features:
96-well, 5-color real-time PCR
Designed for in vitro diagnostic use
High-resolution melting analysis capabilities
Robust performance with validated Fast reagents
The ABI 7500 Real-Time PCR System family provides options to meet the diverse needs of clinical and analytical labs.
Send us a quote request today and we’ll provide your total cost of ownership to upgrade your lab.
More runs per day with Applied Biosystems 7500
The ABI 7500 delivers high quality results in 30 minutes and comes with intuitive software to streamline your data analyses.
Here are some features that set it apart from other thermal cyclers:
Fast ramp rates enable rapid results without compromising extension times or assay quality.
Simplify experimental design and setup with setup wizards and multiplate data viewing.
One-click export to PowerPoint or JPEG streamlines data processing and presentation.
Email notifications upon run completion reduce the need for constant monitoring.
Fast optical plates ensure excellent precision in small reaction volumes (5-30 μL).
Automatic start for maintenance and QC tasks further reduces manual workload.
Get a quote today to see your total cost of ownership and increase your lab’s PCR capacity.
2019 Sysmex XN 550 - available immediately
2019 Sysmex XN 550 - available immediatelyApplied Biosystems 7500 for clinical labs
Molecular microbiology vs traditional microbiology test
Worried about missing colony counts and ASTs?
The good news is that physicians often prefer fast turnaround on pathogen ID and resistance markers rather than waiting for traditional micro results.
Molecular microbiology testing is definitely the way to future diagnostic testing.
Here’s why the ABI 7500 is an excellent choice for clinical labs:
Efficiency and speed
Increase throughput with faster results, allowing for more runs per day and greater productivity.
Adapt to various research applications with one system, providing reliable performance across different assays.
Versatility
Supports a wide range of applications including gene expression analysis, absolute quantitation, SNP genotyping, and high-resolution melting (HRM) analysis.
Optimized for standard dye sets (FAM™, SYBR® Green I, VIC®/JOE™, NED™, TAMRA™, ROX™, Cy3™, and Cy5™) for flexibility in experimental design.
Regulatory compliance
SDS v1.4 21 CFR Part 11 Module for compliance assistance ensures adherence to regulatory standards.
User log-ins and customizable permission settings maximize control over data security and traceability.
Reliable & accurate results with Applied Biosystems 7500
The ABI 7500 Fast Real-Time PCR System ensures reliable and accurate test results through several key features:
Advanced optical system
Facilitates easy calibration for new dyes and minimizes spectral crosstalk, enhancing multiplexing capabilities.
High-quality reagents and assays
Access to a comprehensive suite of over 700,000 TaqMan® Gene Expression Assays and 4.5 million SNP Genotyping Assays, with custom designs for high precision.
Thermal uniformity
A specially designed fast block ensures thermal uniformity at high speeds, providing consistent results. Fast optical plates and ramp rates further contribute to precision in small reaction volumes.
Save lab budget with Applied Biosystems 7500
The ABI 7500 PCR System is designed to help labs save on costs through several key features:
- Save on reagents: Fast optical plates and reagents for small reaction volumes (5-30 μL) minimize reagent use. Fast ramp rates also reduce overall energy consumption by shortening run times without compromising quality.
- Low maintenance: Extensive validation support, including IQ/OQ with certified service engineers, minimizes downtime and maintenance costs. 21 CFR Part 11 compliance features reduce the risk of regulatory non-compliance.
- Long-term investment: The system’s reliable performance and versatility across various applications reduce the need for multiple specialized instruments. Additionally, a comprehensive suite of pre-designed TaqMan® assays minimizes assay optimization effort and expense, providing cost-effective research solutions.
Get a quote today to see your total cost of ownership and increase your lab’s PCR capacity.
Applied Biosystems 7500 applications
The ABI 7500 Fast Real-Time PCR System is designed to support a wide range of applications, making it an invaluable tool for both clinical and analytical laboratories.
Gene expression analysis
Quantify gene expression levels with high precision.
Perform relative and absolute quantification.
Utilize over 700,000 pre-designed TaqMan® Gene Expression Assays.
Absolute quantitation
Achieve accurate and reproducible quantitation
of nucleic acids.
Suitable for detecting and measuring specific DNA
and RNA targets.
Ideal for applications requiring precise quantification of copy numbers.
SNP genotyping
Detect single nucleotide polymorphisms (SNPs)
with high accuracy.
Use TaqMan® SNP Genotyping Assays for flexible
and reliable genotyping.
Supports large-scale genotyping studies and personalized medicine research.
High-resolution melting (HRM) analysis
Perform high-resolution melting analysis to identify genetic variations.
Suitable for mutation scanning, methylation analysis, and genotyping.
Utilize the new Applied Biosystems HRM Software for precise and sophisticated analysis.
Pathogen detection
Rapidly detect and quantify pathogens in clinical and environmental samples.
Suitable for virology, bacteriology, and mycology studies.
High sensitivity and specificity ensure reliable pathogen identification.
Copy number variation (CNV) analysis
Detect and quantify copy number variations with precision.
Useful for genetic research, cancer studies,
and developmental biology.
Supports high-throughput CNV analysis with reliable results.
+/– Assays utilizing internal positive controls
Conduct qualitative assays with built-in controls
for enhanced accuracy.
Suitable for detecting the presence or absence
of specific genetic targets.
Ensures reliable and consistent results in diagnostic applications.
Sell us your old instruments!
Sell us your instruments and the cost of your ABI 7500 becomes even more manageable. We make equipment sales easy for you.
We give you a competitive value on your equipment based on set parameters
You get a clear payment timeframe and no hidden clauses
We assist with the decontamination plus we arrange
and pay for all shipping changes. Your process is hassle free.
Applied Biosystems PCR systems service
& repairs
Nationwide, onsite service is available on Applied Biosystems instruments. We can give you:
- Customized on-site annual service contracts
- Professional installation
- Equipment familiarization following your installation
Time and material service visits, if your ABI equipment is not under our service contract.
 MYCO offers quick and responsive services for ABI PCR systems
MYCO offers quick and responsive services for ABI PCR systemsWho supplies your reagents today?
Ask us to include the cost of your first 6-12 months of reagents with your quote.
Most labs save 10-15% on ABI PCR system reagents and consumables when they partner with us.
You can see your total cost today and make an informed decision.
Unlike other suppliers who offer tiered pricing favoring the largest customers, we provide the same great
deals to every customer, regardless of lab size. This means 9 out of 10 labs benefit from pricing they
wouldn't qualify for elsewhere.
See your total cost of ownership
Product Overview
The Applied Biosystems® 7500 Fast Real-Time PCR System offers maximum performance in the minimum time. Fully optimized for Fast cycling, the 7500 Fast delivers high-quality results in as little as 30 minutes. We supply a Dell™ Notebook computer with the 7500 Fast System.
• Specially designed Fast block ensures thermal uniformity at top speeds.
• Faster ramp rates enable rapid results without compromising extension times or assay quality.
• Fast optical plates ensure excellent precision in 10-30 ul reaction volumes.
• Use TaqMan® Fast Universal PCR Master Mix to run multiple Fast assays on one plate.
• Finish more runs per day with the excellent performance equivalent to that offered by the 7500 System.
High Resolution Melting Analysis
The Applied Biosystems® High Resolution Melting (HRM) Software is the easiest to use melting analysis software enabling real-time PCR melt curve assays to be used more accurately for mutation scanning and genotyping. The HRM Software is available on the 7500 Fast Real-Time PCR System, which delivers precise results in a standard 96-well format.
Use the Applied Biosystems® High Resolution Melting (HRM) Software to perform more sophisticated melting analysis with an easy to follow workflow and minimal subjective data analysis steps.
• Shortens analysis time by auto-calling genotypes and automatically omitting the no template controls.
• Minimizes subjective analysis by automatically grouping unknown variant clusters.
• No temperature shift required – distinguish between homozygous mutants and wild type more easily.
• Allows easy data review with customizable multi-plot views, expandable windows and one-click color assignment to highlight curves of interest.
• Facilitates data presentation with the option to export data and graphs directly to PowerPoint or as JPEG files.
NEW - 7500 Software v2.0
Now the easy-to-use StepOne software is available for both the 7500 and 7500 Fast systems with the 7500 Software v2.0 upgrade. The 7500 Software v2.0 incorporates your favorite StepOne Software features, such as a variety of plate setup wizards, standard curve dilution and master mix recipe calculators, QC flags, data filters, and email notification when a run is finished. The 7500 Software v2.0 also includes an enhanced Gene Expression Study package and has a variety of new melting curve protocol options, including multiple peak detection, step and hold temperature control, and customizable ramp rates.
The Gene Expression Study package accommodates large studies better than any other instrument software package:
• Import an unlimited number of Comparative CT (relative quantitation) files to one study.
• Group samples and view data both by technical replicate group and biological replicate group.
• Use any gene(s) as an endogenous control, including averaging multiple controls together.
• Enter known efficiency values to be factored into the RQ results
21 CFR Part 11 Module available
The SDS v1.4 21CFRp11 Module is a powerful tool for assisting with 21CFRp11 compliance, while still offering the flexibility of user-customizable configuration settings.
• Individual user log-ins can be added for up to four user groups, each group with designated permission settings.
• User-customizable permission settings include fourteen system activities, e-signature authority designation, and additional security settings to give you maximum control over your compliance efforts.
• Audit trails can be enabled or disabled depending on your traceability needs.
• A selection of e-signatures is available to ease e-signatures into your workflow.
One System, Many Applications
Applications include gene expression analysis, pathogen quantitation, SNP genotyping, isothermal and +⁄– assays utilizing internal positive controls. To facilitate many of these applications, Applied Biosystems® provides preformulated, ready-to-use, quality-tested, TaqMan® assays for use with the 7500 Fast system. Now you can reduce your assay optimization efforts.
For Research Use Only. Not for use in diagnostics procedures.
Related Documents
- Tfs Assets Lsg Manuals Cms 053412.Pdf
- Tfs Assets Lsg Manuals Cms 050637.Pdf
- Tfs Assets Lsg Manuals 4387785C.Pdf
- Tfs Assets Lsg Manuals 4387784C.Pdf
- Tfs Assets Lsg Manuals 4387783C.Pdf
- Tfs Assets Lsg Manuals 4387779 7500 Stndcrv Gsg 25Oct2016.Pdf
- Tfs Assets Lsg Manuals 4387778A.Pdf
- Tfs Assets Lsg Manuals 4387777D.Pdf
- Tfs Assets Lsg Manuals 4387776A.Pdf
- Tfs Assets Lsg Manuals 7500 7500 Fastreal Pcr Stdcurve Ug.Pdf
- Tfs Assets Lsg Specification Sheets Cms 066693.Pdf
- Tfs Assets Lsg Brochures Cms 072493.Pdf

















